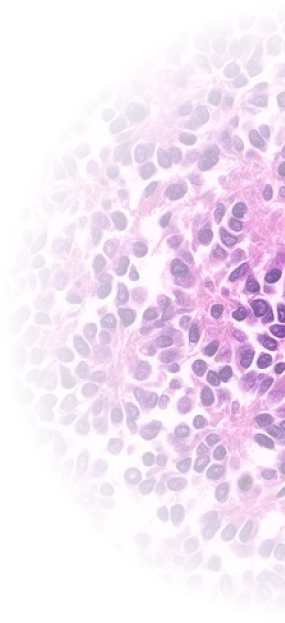
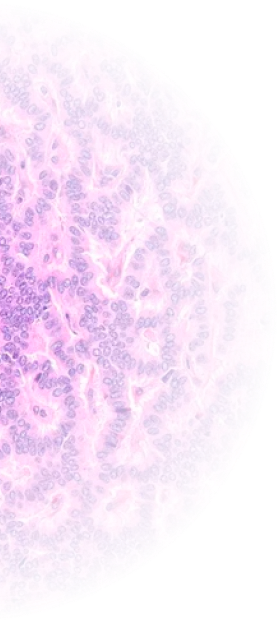

Современные подходы в диагностической и предиктивной патологии для
оптимизации лечения пациентов
О конференции
Международная научно-практическая конференция «Современные подходы в диагностической и предиктивной патологии для оптимизации лечения пациентов» посвящена современным вопросам патоморфологической диагностики и роли предиктивной патологии в персонализированном выборе терапии. В работе конференции примут участие ведущие зарубежные эксперты из США, Европы и стран СНГ.
В рамках конференции будут представлены следующие направления:
Патология костей и мягких тканей
Патология головы и шеи
Гинекологическая патология
Гематопатология
Нейропатология
Нефропатология
Конференция будет полезна как патоморфологам, так и врачам клинических специальностей. Совместное обсуждение сложных случаев и современных диагностических подходов способствует более обоснованному выбору тактики лечения и выстраиванию эффективного взаимодействия между специалистами вокруг одного пациента.
Спикеры
Программа
Скачать программуРегистрация участников
Приветственное слово
Спикер: Botiralieva Gulrux, Ph.D., Abduvoitov Umarbek NO PhD
Классификация опухолей: теория и практика (WHO)
Спикер: Alexander J. Lazar, M.D., Ph.D.
Диагностический подход к гемопатологии: текущее состояние и перспективы
Спикер: Kirill Lyapichev, M.D.
Обновления в классификации Т-клеточных лимфом
Спикер: Roberto N. Miranda, M.D.
Кофе-брейк
Дифференциальная диагностика миоэпителиальных опухолей
Спикер: Lester Daron Robert Thompson, M.D.
Опухоли слюнных желез: иммуногистохимический профиль
Спикер: Abbas Agaimy, M.D.
Молекулярная классификация меланоцитарных новообразований
Спикер: Amir Behdad, M.D.
Обед
Новые нозологические единицы по профилированию метилирования ДНК
Спикер: Maria Gubbiotti, M.D., Ph.D.
Клинические кейсы: примеры из практики
Спикер: Konovalov Dmitriy Mixaylovich, M.D., Ph.D.
Моноклональные гаммопатии почечной значимости.
Спикер: Rajan Duggal, M.D.
Моноклональные гаммопатии почечной значимости.
Спикер: Botiraliyeva Gulrux, M.D., Ph.D.
Гала-ужин
Организаторы


Партнеры
Контакты
Организационный комитет конференции
Проживание
Информация о гостиницах, условиях размещения и контактах службы бронирования доступна в отдельном разделе.
Перейти к разделу «Проживание»Тур в Бухару
Подробная информация о культурной программе, контактах и условиях бронирования тура в Бухару представлена в отдельном разделе.
Перейти к разделу «Тур в Бухару»Оплата и документы
Принимаем к оплате
 Visa
VisaMastercard

UnionPay
 Uzcard
Uzcard
Humo